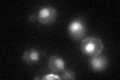
YKL113C
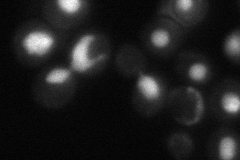
YKL113C

View description
5' to 3' exonuclease, 5' flap endonuclease, required for Okazaki fragment processing and maturation as well as for long-patch base-excision repair; member of the S. pombe RAD2/FEN1 family
Localization:
Intensity:
Fold change:
Significance:
-
C’ GFP library in SD
nucleus34.78 -
N' NOP1pr-GFP in SD

nucleus170.01 -
N' TEF2pr-mCherry in SD

nucleus261.296 -
N' NATIVEpr-GFP in SD
nucleus47.1465 -
N' TEF2pr-VC and Cyto-VN in SD

#N/A0 -
C’ GFP library in SD+DTT

nucleus24.160.69Yes -
C’ GFP library in SD+H2O2

nucleus37.51.07No -
C’ GFP library in Starvation Media

nucleus43.071.23No -
C’ GFP library on the background of Pup2-DaMP

nucleus -
C’ GFP library on the background of CCT mutant

nucleus34.54240.993019No
